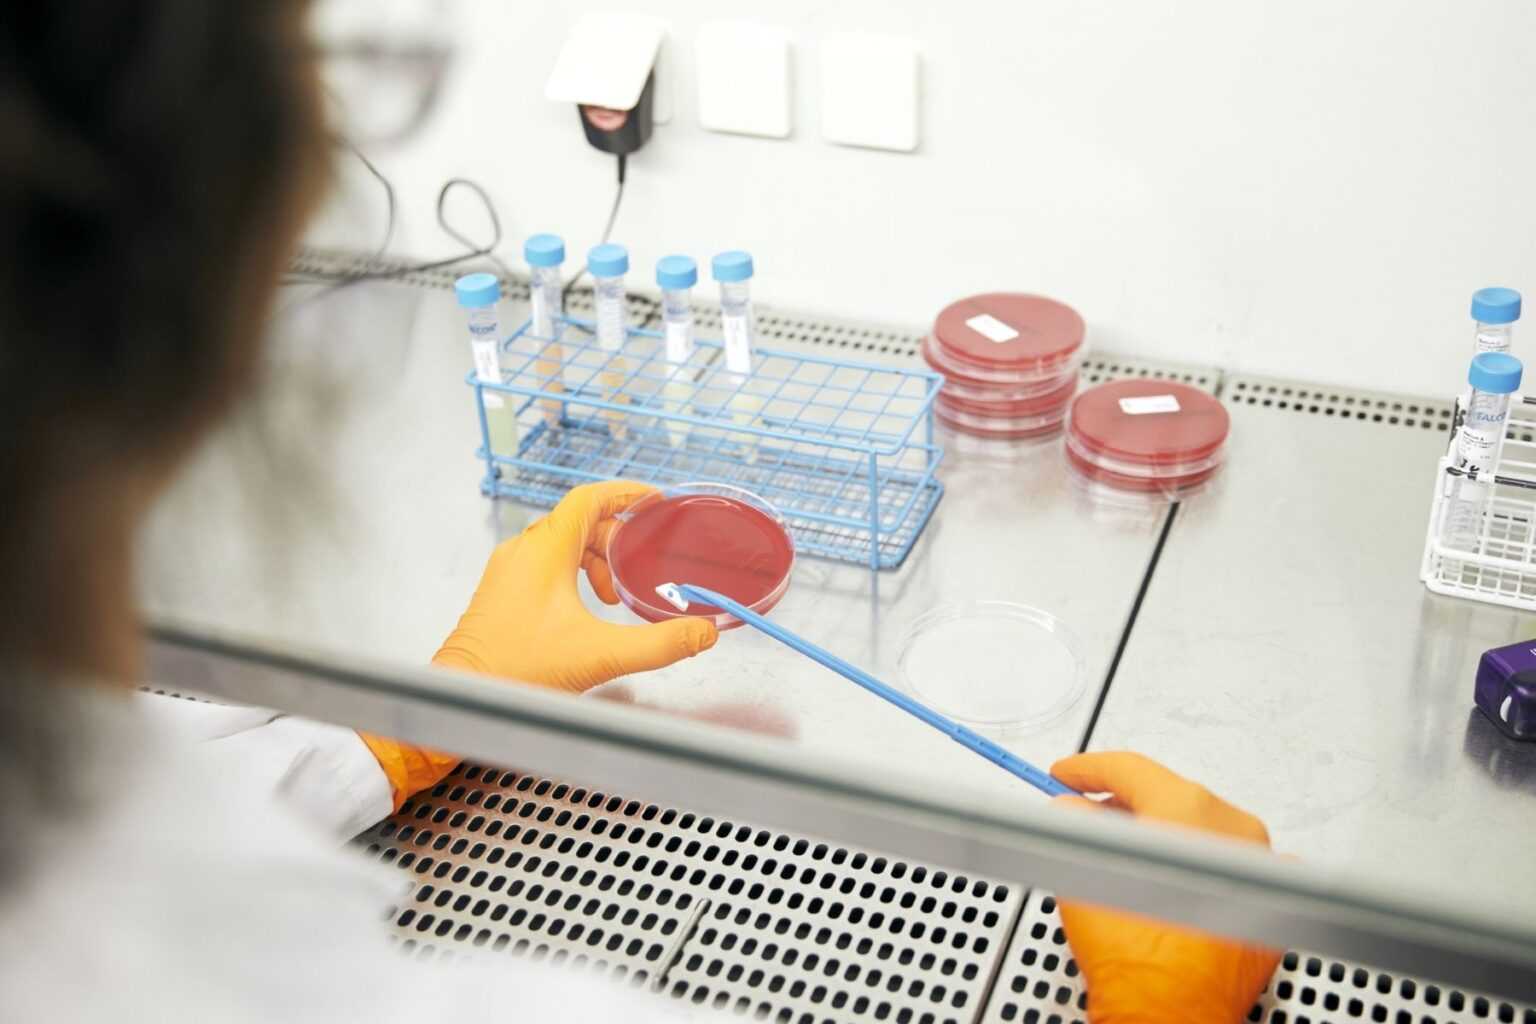

Η αντι-ιική ικανότητα της ρεμδεσιβίρης έναντι του SARS-CoV-2 παραμένει σχετικά αμφιλεγόμενη. Οι Ιατροί της Θεραπευτικής Κλινικής της Ιατρικής Σχολής του Εθνικού και Καποδιστριακού Πανεπιστημίου Αθηνών, Θεοδώρα Ψαλτοπούλου, Γιάννης Ντάνασης, Πάνος Μαλανδράκης και Θάνος Δημόπουλος (Πρύτανης ΕΚΠΑ) συνοψίζουν τα αποτελέσματα της σχετικής κλινικής μελέτης DisCoVeRy που δημοσιεύτηκε πρόσφατα στο έγκριτο επιστημονικό περιοδικό The Lancet Infectious Diseases (DOI:https://doi.org/10.1016/S1473-3099(21)00485-0).

Πρόκειται για μια τυχαιοποιημένη μελέτη φάσης 3, πολυκεντρική, η οποία πραγματοποιήθηκε σε 48 κέντρα στην Ευρώπη (Γαλλία, Βέλγιο, Αυστρία, Πορτογαλία, Λουξεμβούργο). Στη μελέτη συμμετείχαν ενήλικες ασθενείς με εργαστηριακά επιβεβαιωμένη λοίμωξη COVID-19 και στοιχεία πνευμονίας με υποξυγοναιμία ή ανάγκη για συμπληρωματικό οξυγόνο. Οι συμμετέχοντες τυχαιοποιήθηκαν να λάβουν την κλασική υποστηρικτική θεραπεία μόνο είτε σε συνδυασμό με τη ρεμδεσιβίρη ή με λοπιναβίρη-ριτοναβίρη ή λοπιναβίρη-ριτοναβίρη και ιντερφερόνη βήτα 1α ή υδροξυχλωροκίνη. Η ρεμδεσιβίρη χορηγήθηκε ως ενδοφλέβια έγχυση στα 200mg την ημέρα 1 και ακολούθως στα 100mg την ημέρα για τις επόμενες 9 ημέρες. Το πρωτεύον καταληκτικό σημείο της μελέτης ήταν η κλινική κατάσταση των ασθενών την 15η ημέρα νοσηλείας και η ασφάλεια των συνδυασμών.

Μεταξύ 22 Μαρτίου 2020 και 21 Ιανουαρίου 2021, 857 ασθενείς εντάχθηκαν στη μελέτη. Η ανάλυση βασίστηκε σε 414 ασθενείς που έλαβαν ρεμδεσιβίρη μαζί με την υποστηρικτική αγωγή και σε 418 που έλαβαν μόνο υποστηρικτική αγωγή. Την 15η ημέρα νοσηλείας η κατανομή των ασθενών ανά κατηγορία κλινικής κατάστασης ήταν ως εξής: (1) μη νοσηλευόμενοι, χωρίς περιορισμούς στις καθημερινές δραστηριότητες – 61 (15%) στην ομάδα της ρεμδεσιβίρης έναντι 73 (17%) στην ομάδα ελέγχου, (2) μη νοσηλευόμενοι, με περιορισμούς στις καθημερινές δραστηριότητες – 129 (31%) στην ομάδα της ρεμδεσιβίρης έναντι 132 (32%) στην ομάδα ελέγχου, (3) νοσηλευόμενοι, χωρίς ανάγκη υποστήριξης με οξυγόνο – 50 (12%) στην ομάδα της ρεμδεσιβίρης έναντι 29 (7%) στην ομάδα ελέγχου, (4) νοσηλευόμενοι, με ανάγκη υποστήριξης με οξυγόνο – 76 (18%) στην ομάδα της ρεμδεσιβίρης έναντι 67 (16%) στην ομάδα ελέγχου, (5) νοσηλευόμενοι, που λάμβαναν μη επεμβατικό μηχανικό αερισμό ή οξυγόνο με ρινική κάνουλα υψηλής ροής – 15 (4%) στην ομάδα της ρεμδεσιβίρης έναντι 14 (3%) στην ομάδα ελέγχου, (6) νοσηλευόμενοι, υπό επεμβατικό μηχανικό αερισμό ή οξυγόνωση μέσω εξωσωματικής μεμβράνης (ECMO) – 62 (15%) στην ομάδα της ρεμδεσιβίρης έναντι 79 (19%) στην ομάδα ελέγχου, (7) θάνατος – 21 (5%) στην ομάδα της ρεμδεσιβίρης έναντι 24 (6%) στην ομάδα ελέγχου.
Η διαφορά μεταξύ των δύο ομάδων (με ή χωρίς ρεμδεσιβίρη) δεν ήταν στατιστικά σημαντική. Επιπλέον, δεν παρατηρήθηκε στατιστικά σημαντική διαφορά στην εμφάνιση σοβαρών ανεπιθύμητων παρενεργειών στις δύο ομάδες ασθενών (33% στην ομάδα της ρεμδεσιβίρης έναντι 31% στην ομάδα ελέγχου). Μεταξύ των ασθενών που έλαβαν ρεμδεσιβίρη, μόνο ένας θάνατος σε έδαφος ηπατονεφρικού συνδρόμου συσχετίστηκε με το φάρμακο.
- Συμπερασματικά, η συγκεκριμένη μελέτη δεν ανέδειξε κλινικό όφελος από την προσθήκη της ρεμδεσιβίρης σε ασθενείς που νοσηλεύτηκαν λόγω COVID-19, είχαν συμπτώματα για τουλάχιστον 7 ημέρες και είχαν ανάγκη από υποστήριξη με οξυγόνο.